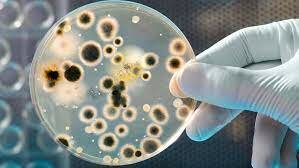
EDAD PATOGÉNICA

-
 El microscopio permitió la observación de "diminutos bichos"
El microscopio permitió la observación de "diminutos bichos"
de un mundo desconocido, existiendo en agua, suelos, animales, plantas, incluyendo el mismo hombre -
 informó al mundo que las unidades estructurales más pequeñas de la vida eran “celdillas pequeñas” o “células”, como él las denominó. Mediante el empleo de su versión mejorada de un microscopio compuesto (con dos juegos de lentes),
informó al mundo que las unidades estructurales más pequeñas de la vida eran “celdillas pequeñas” o “células”, como él las denominó. Mediante el empleo de su versión mejorada de un microscopio compuesto (con dos juegos de lentes), -
 demostró que los gusanos no surgían espontáneamente de la carne en descomposición.
demostró que los gusanos no surgían espontáneamente de la carne en descomposición.
Redi llenó dos frascos con carne descompuesta.
El primero quedó abierto; las moscas depositaron sus huevos
en la carne y los huevos se desarrollaron hasta convertirse en
larvas. El segundo frasco quedó sellado y como las m oscas no
podían depositar sus huevos en la carne, no aparecieron gusanos. -
 Es quien haya sido el primero en observar realmente microorganismos vivos a través de las lentes de aumento con
Es quien haya sido el primero en observar realmente microorganismos vivos a través de las lentes de aumento con
las que construyó más de 400 microscopios. Entre 1673 y
1723 van Leeuwenhoek escribió una serie de cartas a la Royal
Society de Londres con la descripción de los “animáculos”,
que vio a través de su microscopio simple -
 descubrió que aun después haber calentado líquidos
descubrió que aun después haber calentado líquidos
nutritivos (caldo de pollo y caldo de cereales) antes de
verterlos en frascos cubiertos las soluciones enfriadas eran
rápidamente invadidas por microorganismos. Needham afirmó
que los microbios se desarrollaban espontáneamente de
los líquidos -
 demostró que en los líquidos nutritivos calentados después de
demostró que en los líquidos nutritivos calentados después de
haber sellado el frasco no se producía crecimiento microbiano
alguno -
 Probó con éxito la primera vacuna de la historia, que fue la de la Viruela, erradicándola
Probó con éxito la primera vacuna de la historia, que fue la de la Viruela, erradicándola -
La demostración de la conexión entre el deterioro de los alimentos y los microorganismos fue un paso fundamental hacia el establecimiento de la relación entre la enfermedad y los microbios
La demostración de la conexión entre el deterioro de los alimentos y los microorganismos fue un paso fundamental hacia el establecimiento de la relación entre la enfermedad y los microbios -
 descubrió que la "muscardina" o "mal del segno" (una enfermedad del gusano de seda) era causada por un muy pequeño organismo parasítico, un hongo que eventualmente se llamaría Beauveria bassiana en su honor.
descubrió que la "muscardina" o "mal del segno" (una enfermedad del gusano de seda) era causada por un muy pequeño organismo parasítico, un hongo que eventualmente se llamaría Beauveria bassiana en su honor. -
 obstetra húngaro, logró descubrir la naturaleza infecciosa de la fiebre puerperal, logrando controlar su aparición con una simple medida de antisepsia.
obstetra húngaro, logró descubrir la naturaleza infecciosa de la fiebre puerperal, logrando controlar su aparición con una simple medida de antisepsia. -
 avances rápidos encabezados sobre todo por Pasteur y Robert Koch que condujeron al establecimiento de la microbiología como ciencia. Durante esos años se descubrieron los agentes causales de muchas enfermedades y se estableció el papel de la inmunidad en la prevención y la curación de patologías
avances rápidos encabezados sobre todo por Pasteur y Robert Koch que condujeron al establecimiento de la microbiología como ciencia. Durante esos años se descubrieron los agentes causales de muchas enfermedades y se estableció el papel de la inmunidad en la prevención y la curación de patologías -
 desafió la generación espontánea
desafió la generación espontánea
con el concepto de biogénesis, la afirmación de que las
células vivas sólo podían surgir de células vivas preexistentes -
 demostró que los microorganismos están presentes en
demostró que los microorganismos están presentes en
el aire y pueden contaminar soluciones estériles pero que el
aire per se no crea los microbios -
 descubrió la causa del carbunco, enfermedad que estaba destruyendo al ganado bovino y ovino en Europa. La bacteria con forma de bastón que ahora conocemos como Bocillus anthracis en la sangre de los animales muestos con carbunco
descubrió la causa del carbunco, enfermedad que estaba destruyendo al ganado bovino y ovino en Europa. La bacteria con forma de bastón que ahora conocemos como Bocillus anthracis en la sangre de los animales muestos con carbunco -
 Pasteur descubrió el modo en que actúan las vacunas.
Pasteur descubrió el modo en que actúan las vacunas.
Descubrió que la bacteria que produce el cólera aviario perdía
su capacidad de causar enfermedad (pérdida de su virulencia
o conversión en avirulenta) después de ser cultivada en el laboratorio duran te períodos prolongados. Sin embargo este microorganismo (así como otros con disminución de la virulencia), podía inducir inmunidad contra infecciones ulteriores por cepas virulentas. -
 primer científico en describir las características de una entidad acelular que denominó virus. Informó que el microorganismo causante de la enfermedad del mosaico del tabaco era tan diminuto que atravesaba filtros los bastantes finos como para impedir el paso de todas las bacterias conocidas.
primer científico en describir las características de una entidad acelular que denominó virus. Informó que el microorganismo causante de la enfermedad del mosaico del tabaco era tan diminuto que atravesaba filtros los bastantes finos como para impedir el paso de todas las bacterias conocidas. -
 había encontrado un hongo capaz de inhibir el crecimiento de una bacteria. Este hongo fue identificado más tarde como Penicillium chrysogenum y en 1928 Fleming denominó penicilina a este inhibidor activo de los hongos. Por lo tanto, la penicilina es un antibiótico producido por un hongo. Su enorme utilidad no se evidenció hasta la década de 1940, cuando por fin fue evaluada en ensayos clínicos y producida en forma masiva.
había encontrado un hongo capaz de inhibir el crecimiento de una bacteria. Este hongo fue identificado más tarde como Penicillium chrysogenum y en 1928 Fleming denominó penicilina a este inhibidor activo de los hongos. Por lo tanto, la penicilina es un antibiótico producido por un hongo. Su enorme utilidad no se evidenció hasta la década de 1940, cuando por fin fue evaluada en ensayos clínicos y producida en forma masiva. -
 clasificación de los estreptococos según serotipos, sobre la base de cientos componentes de la pared celular de las bacterias. Los estreptocococos causan una diversidad de enfermedades, como angina, shock tóxico estreptocócico y septicemia. Su investigación permite la identificación rápida de estreptococos patógenos específicos por medio de técnicas inmunológicas.
clasificación de los estreptococos según serotipos, sobre la base de cientos componentes de la pared celular de las bacterias. Los estreptocococos causan una diversidad de enfermedades, como angina, shock tóxico estreptocócico y septicemia. Su investigación permite la identificación rápida de estreptococos patógenos específicos por medio de técnicas inmunológicas. -
 relación genes - enzimas
relación genes - enzimas -
 modelo de la estructura y la replicación del ADN. En 1960 se produjo una nueva explosión de descubrimientos relacionados con el modo en que el ADN controla la síntesis de proteínas
modelo de la estructura y la replicación del ADN. En 1960 se produjo una nueva explosión de descubrimientos relacionados con el modo en que el ADN controla la síntesis de proteínas -
 ADN = MATERIAL GENETICO
ADN = MATERIAL GENETICO -
el material genético podía transferirse de una bacteria a otra mediante un proceso denominado conjugación
-
 En el ARN mensajero, descubren una sustancia química implicada en la síntesis proteica y con posterioridad realizaron las primeras observaciones importantes sobre la regulación del funcionamiento de los genes de las bacterias
En el ARN mensajero, descubren una sustancia química implicada en la síntesis proteica y con posterioridad realizaron las primeras observaciones importantes sobre la regulación del funcionamiento de los genes de las bacterias -
 El virus de Epstein-Barr (EBV) es un virus del herpes γ humano. Es el agente causante de enfermedades como la Mononucleosis Infecciosa y se asocia a varios síndromes inmunoproliferativos. A diferencia de otros virus del herpes, como el herpes simple, no existe un tratamiento contra el VEB.
El virus de Epstein-Barr (EBV) es un virus del herpes γ humano. Es el agente causante de enfermedades como la Mononucleosis Infecciosa y se asocia a varios síndromes inmunoproliferativos. A diferencia de otros virus del herpes, como el herpes simple, no existe un tratamiento contra el VEB. -
 dos microbiólogos, constituyeron la base del conocimiento actual de los ciclos bioquímicos que mantienen la vida sobre la tierra. Mantinus Beijetinck y Sergel Winograsky fueron los primeros en demostrar que las bacterias contribuyen el reciclado de elementos vitales entre el suelo y la atmósfera. La ecología microbiana, el estudio de los microorganismos y su ambiente.
dos microbiólogos, constituyeron la base del conocimiento actual de los ciclos bioquímicos que mantienen la vida sobre la tierra. Mantinus Beijetinck y Sergel Winograsky fueron los primeros en demostrar que las bacterias contribuyen el reciclado de elementos vitales entre el suelo y la atmósfera. La ecología microbiana, el estudio de los microorganismos y su ambiente. -
 Clasifica el árbol de la vida en tres grupos, en la categoría más alta: Bacteria (en sentido restringido, excluyendo a las arqueas, a diferencia de la hasta en ese momento concepción del grupo), Archaea y Eukarya. Woese se basó en las diferencias encontradas en la secuencia del ARN ribosomal de la subunidad menor, para concluir que estos grupos se desarrollaron por separado de un progenitor común llamado progenote.
Clasifica el árbol de la vida en tres grupos, en la categoría más alta: Bacteria (en sentido restringido, excluyendo a las arqueas, a diferencia de la hasta en ese momento concepción del grupo), Archaea y Eukarya. Woese se basó en las diferencias encontradas en la secuencia del ARN ribosomal de la subunidad menor, para concluir que estos grupos se desarrollaron por separado de un progenitor común llamado progenote. -
 El virus del mosaico del tabaco tiene una apariencia de varilla. Su cápside está hecha de 2130 moléculas de proteína de recubrimiento y una molécula de ARN genómico de una sola hebra, de 6400 bases de largo.
El virus del mosaico del tabaco tiene una apariencia de varilla. Su cápside está hecha de 2130 moléculas de proteína de recubrimiento y una molécula de ARN genómico de una sola hebra, de 6400 bases de largo. -
 comenzaron a utilizar microbios para eliminar contaminantes y desechos tóxicos producidos por diversos procesos industriales
comenzaron a utilizar microbios para eliminar contaminantes y desechos tóxicos producidos por diversos procesos industriales -
 Descubrió una bacteria lo suficientemente grande como para ser observada a simple vista (o,2mm de ancho). Esta bacteria denominada Thiomargarita nomibiensis, vive en el lodo de las costas africanas, consume sulfuro de hidrógeno, que podría ser tóxico para los animales que residen en el lugar
Descubrió una bacteria lo suficientemente grande como para ser observada a simple vista (o,2mm de ancho). Esta bacteria denominada Thiomargarita nomibiensis, vive en el lodo de las costas africanas, consume sulfuro de hidrógeno, que podría ser tóxico para los animales que residen en el lugar
Want to make a timeline like this?
Use Timetoast to turn dates, events, milestones, and phases into a clear visual timeline you can build and share. Timetoast is a timeline maker for work, school, research, and stories.